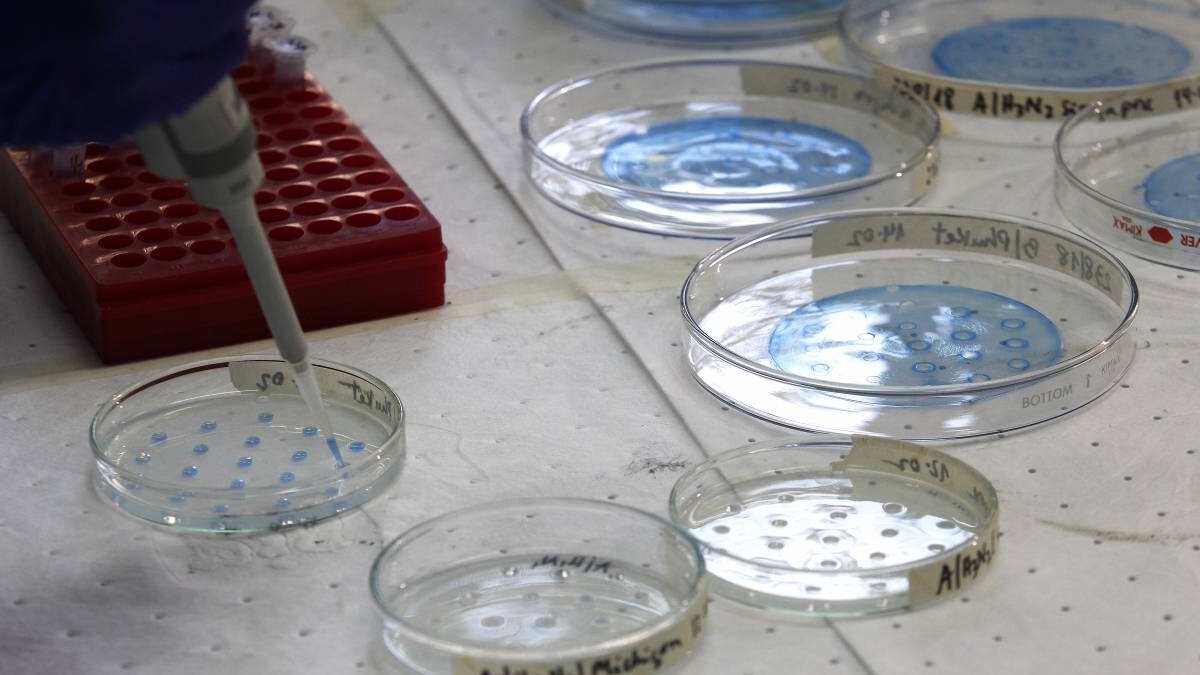

El Ministerio de Salud dio a conocer este domingo un nuevo reporte con los casos de coronavirus en el país.
Al respecto, el Minsal informó que en las últimas 24 horas se registraron 7.294 contagios de covid.
De dicha cifra son 4.686 casos con síntomas, 2.034 casos asintomáticos y 574 no notificados.
De esta manera se contabilizan 1.124.718 contagios totales desde que inició la pandemia, de los cuales 45.377 son casos activos y 1.053.635 recuperados.
Por último, se reportaron 122 fallecidos a causa de covid en las últimas 24 horas, contabilizándose 25.177 decesos desde que comenzó la crisis.